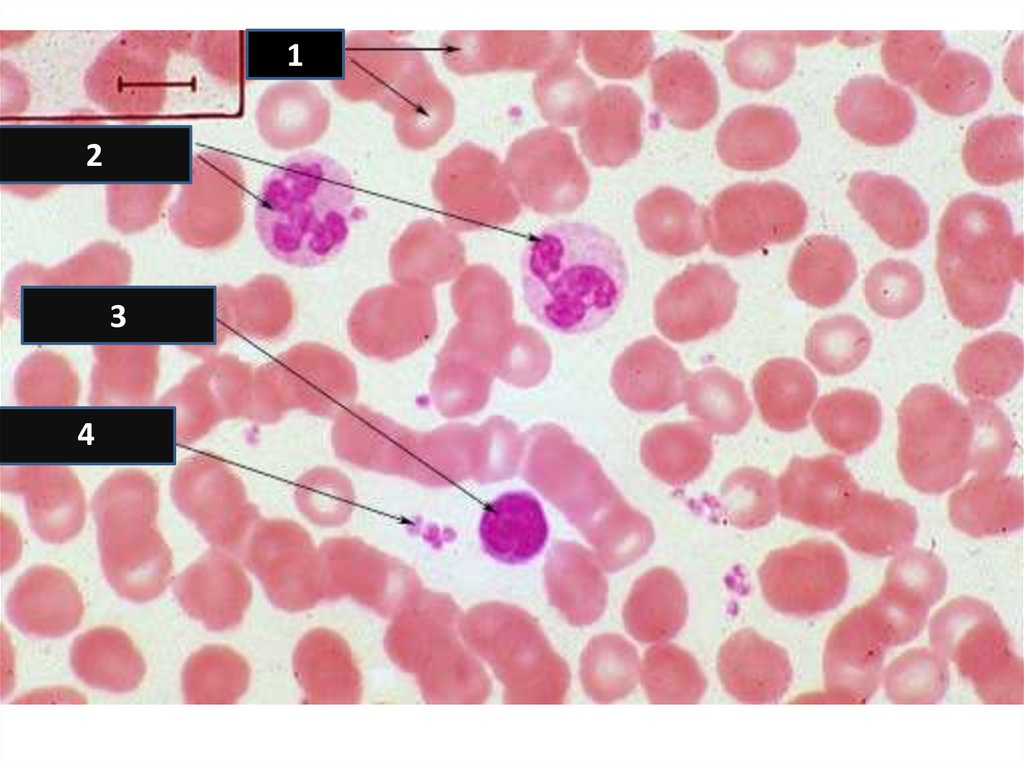
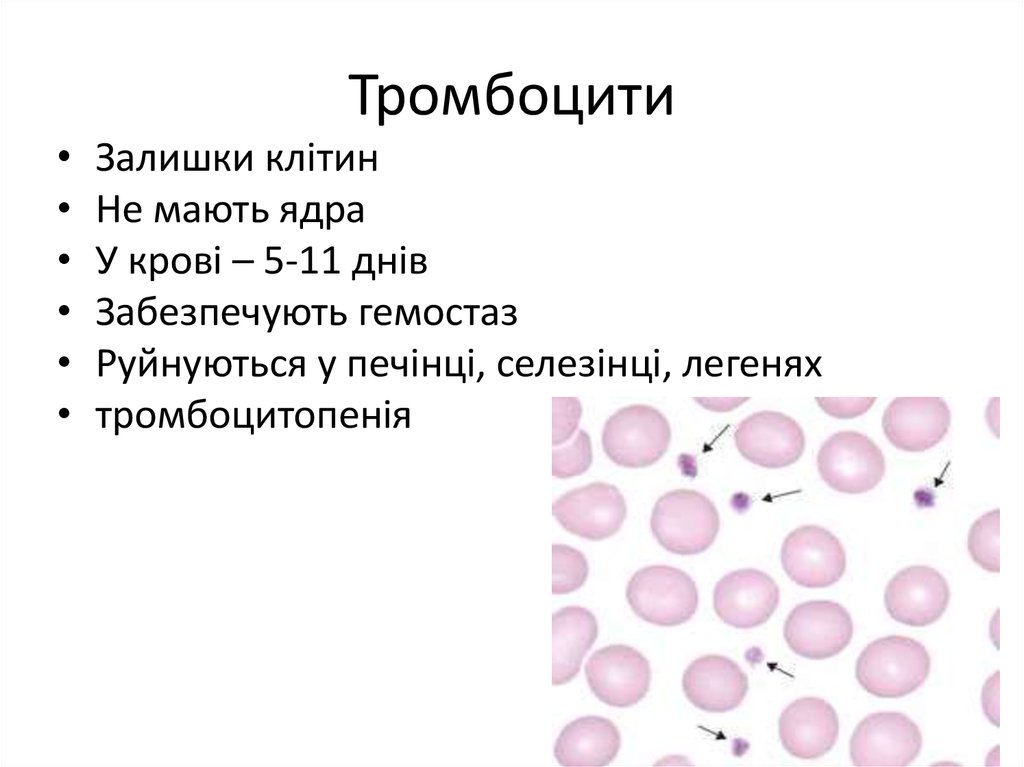
Тромбоцити

Похожие презентации:
Серцево-судинна система
1. Серцево-судинна система
Узагальнення шкільного курсу збіології.
Підготовка до олімпіад.
http://vk.com/biology_145
2. ПОВТОРЕННЯ Назвіть тип тканини та місцезнаходження
12
3
4
3.
1.2.
3.
4.
Яка тканина не має капілярів?
Остеокласти відносяться до … тканини
Скоротливі білки м'язової тканини - …
Клітини власне сполучної тканини
називаються … та …
5. Основний білок епітеліальної тканини - …
6. Волокнистий хрящ присутній у …
7. Клітини глії, що утворюють мієлінову
оболонку: … та …
4. Кров
Плазма = 55%Вода, білки,
транспортні речовини
Формені елементи = 45%
•Еритроцити
•Лейкоцити
•Тромбоцити
5. Плазма
• Білки: альбуміни, глобуліни, фібриноген• Вода – 90%
6. Формені елементи
7. Еритроцити = червоні кров'яні тільця
Переносять кисень
Живуть 120 днів
Утворюються у чкм
Руйнуються у печінці
Анемія, поліцитемія, цитопенія
8.
9.
10.
11.
12. Лейкоцити = білі кров'яні тільця
• Утворюються у чкм• Деякі живуть до десятків років
• Лейкоцитоз, лейкопенія
13.
14.
15.
16.
12
3
4
17. Тільця Барра
18.
19. Тромбоцити
Залишки клітин
Не мають ядра
У крові – 5-11 днів
Забезпечують гемостаз
Руйнуються у печінці, селезінці, легенях
тромбоцитопенія
20.
21.
22.
23.
24.
25.
26.
27.
28. Дякую за увагу
Що тутвідбувається?
Вечірка тромбоцитів!
Вечірка
тромбоцитів!
А що, я роками
так не веселився!
Я думаю,
ми застрягли
Вечірка тромбоцитів!
Вечірка
тромбоцитів!
Ні, серйозно,
ми застрягли
Вечірка тромбоцитів!

Биология
Биология








